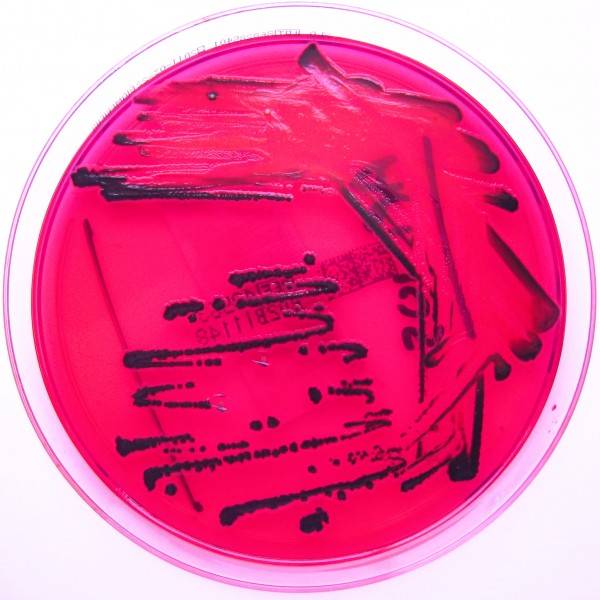

The incredible success of antibiotics in treating life threatening infections has carried a sting in its tail in the form of resistance. The majority of antibiotic use is in the community, however the impact of antibiotic resistance is felt most acutely when treating patients in healthcare settings.
The ready transmission of bacteria between healthcare staff and patients, and between the environment and patients, play a critical role in the acquisition of infections and antibiotic resistance in hospitals. The intensive use of broad spectrum antibiotics in hospitals results in selection pressure on the disease causing pathogens and promotes the emergence of multi drug-resistant bacteria.
Though many of the advanced healthcare systems now have initiated steps to control the use of antibiotics and the spread of infections in the healthcare environment, there are many parts of the world where there continues to be a lack of control over the use of antibiotics. With mass mobilisation of the human population, and the opening of geographical borders, it is essential to put the risk of antibiotic resistance into a global context and move towards a global strategy to monitor antibiotic usage.
The accidental discovery of penicillin by Alexander Fleming, in what is now Imperial College London, changed the course of modern medicine. Fleming stumbled across a substance that he called penicilllin in 1928, but it wasn’t until 1941 in the throes of World War II that the mass production of this naturally occurring substance for medical purposes took hold.
Antibiotic resistance renders antibiotics ineffective and poses a serious threat to how infections are treated
Penicillin became the ‘wonder drug’ of the war and saved the lives of thousands of wounded soldiers. With this drug, doctors were suddenly able to treat previously incurable and fatal infections. With the success of penicillin the search was on for discovering similar agents and the term antibiotic was first coined by John C. Sheehan in 1957, following his success in developing synthetic penicillin.
Antibiotics did, and still do, continue to save millions of lives but it wasn’t long though before this class of ‘wonder’ drug began to lose its luster due to the emergence of resistance. Success came at a cost and antibiotic usage requires careful consideration.
Infections occur as a result of the body being invaded by pathogens. The symptoms of infection are a manifestation of the host’s immune response to eradicating the pathogen. Thus the target of action for antibiotics is not the host but the invading pathogen; this creates a unique medical scenario and sets antibiotics apart from other classes of drugs. They target the invading bacteria and cause minimum damage to the host.
Bacteria, when exposed to antibiotics, can develop resistance and withstand the destructive mechanisms antibiotics use to destroy them. This acquisition of resistance is detrimental to the long-term efficacy of antibiotics and results in collateral damage. Antibiotic resistance renders antibiotics ineffective and poses a serious threat to how infections are treated not only in individual patients but also long-term in populations.
This is of particular concern and poses long-term adverse effects for patient safety as there are not many new agents in the pipeline.1 Unlike, for example, antihypertensive or diabetes medicines where all the drugs in the class can be relied on to have the required effect on diseases outcomes, antibiotics have spectra of activity.
This variation is due to the myriad of different bacteria capable of causing serious infections in humans. The characteristics of these different species of bacteria mean that not all antibiotic drugs can cure all pathogens. Currently in the UK there are 52 licensed anti-infectives with varying spectrum of activity against disease causing bacteria.
Pharmaceutical companies need a financial incentive if they are to invest in research into finding new antibacterial agents. However the increasing focus on using targeted and justified antibiotic therapy, and the reservation of broad spectrum agents, act as a disincentive for big pharma to invest in new agents.
The growing threat of antibiotic resistance and the lack of new drugs pose a serious public health threat when put in the context of emergence of Tuberculosis and serious hospital acquired infections that are now treatable with only a handful of drugs.2 This growing public health concern was highlighted in a recent World Health Organisation (WHO) report earlier this year urging organisations and nations to put into place measures to streamline antibiotic stewardship strategies to tackle the rising tide of resistance.
Antibiotic Exposure
The majority of antibiotic usage is in the community (over 80% of all prescriptions), however, the usage of antibiotics in hospital settings continues to receive a lot of attention, primarily due to hospital acquired infections.
Healthcare acquired infections (HCAI) are defined as infections acquired as a result of ‘healthcare interventions such as medical or surgical treatment, or from being in contact with a healthcare setting’.3 A host of different pathogens are implicated in development of HCAI with the most prevalent pathogens associated with HCAIs being meticillin-resistant Staphylococcus aureus (MRSA), meticillin-sensitive Staphylococcus aureus (MSSA), Clostridium difficile (C.diff) and Escherichia coli (E. coli).3 HCAIs pose a serious threat to the health and wellbeing of patients, staff and carers and their prevention and treatment is a top priority for the National Health Service (NHS).
The hospital environment too plays an important role in the threat of antibiotic resistance and HCAIs. In healthcare settings the transmission of bacteria between patients and staff, and between the contaminated healthcare environment and patients results in higher risks of infection.
In addition, the exposure of bacteria to broad spectrum antibiotics used to treat patients and the opportunity of genetic transfer between different bacteria can bring about resistance through selection pressure on the bacteria.4 Patient morbidity and mortality is higher amongst patients infected with resistant bacteria.
The direct link between antibiotic usage and emergence of antimicrobial resistance is well established.5 6 To combat the rise of HCAI and antibiotic resistance, over the last 10 years, healthcare organisations across the globe have been implementing infection prevention and control and antimicrobial stewardship initiatives.7 8 These initiatives have had varying success and the threat of antibiotic resistance still remains as a major public health threat, as detailed in the WHO report.2
The successes observed in healthcare institutions in some regions of the world for particular infections such as C. diff is offset by the growing concern over emergence of ‘superbugs’ such as E. coli strains reported as being resistant to all but one antibiotic.1
One approach that needs to be considered is whether the fight to conserve the efficacy of antibiotics is extended to all nations and not restricted to those which have advanced health systems and infrastructure to implement local interventions.
Antibiotic Stewardship
Antibiotic stewardship is an umbrella term for a host of different activities undertaken to promote prudent use of antibiotics in healthcare settings. It involves a multidisciplinary collaboration between doctors, pharmacists, nurses, patients and researchers to streamline policies on prescribing of antibiotics and conduct surveillance on the use of antibiotics and the emergence of resistance.
The cornerstone of antimicrobial stewardship initiatives is evidence-based policies to guide the prescription by doctors, the surveillance of antibiotic usage and resistance and a change in the culture of antibiotic usage
The cornerstone of antimicrobial stewardship initiatives is evidence-based policies to guide prescription by doctors, surveillance of antibiotic usage and resistance and a change in the culture of antibiotic usage. These initiatives are relevant and important to the health and wellbeing of patients and can help contribute to efforts to promote judicious use of antibiotics and containment of antibiotic resistance.
Although only 20% of antibiotic usage occurs in hospital settings, it is essential to conduct surveillance of antibiotic use and emergence of resistance in hospitals due to the higher risk of acquiring infections amongst the hospitalised patient population and the greater use of broad spectrum antibiotics in this population.
Furthermore antibiotics used in hospitals are often intravenously administered and are prescribed for longer. The need to get the right therapy for infections in hospital settings means that often antibiotics are started blindly or empirically without any laboratory data to confirm the causative organism.
Increasing reports of multi drug-resistant E.coli strains emerging from healthcare settings and their rapid global spread has created a global public health threat.9 The mass mobilisation of the human population and increases in travel and exposure of people to different healthcare settings means that the term HCAI is no longer to be used in the local context. People can act as the vectors for the global spread of infectious diseases much more rapidly than they could a century or even 50 years ago.
Antibiotic usage remains not well-regulated in the majority of the world, and there needs to be an increased global focus on mechanisms to promote prudent use of antibiotics. We live today in a ‘global village’ and healthcare organisations and governments need to acknowledge this when setting agendas for antibiotic stewardship strategies.








